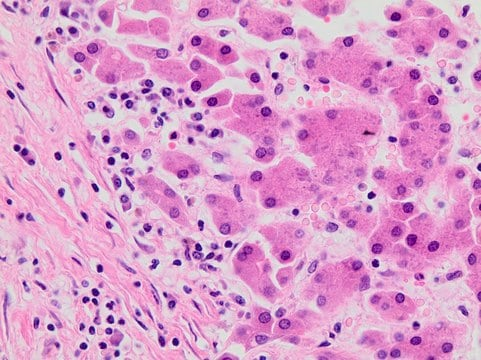
Eosin Y Solution, Alcoholic, 1 X 500 mL (HT110116-500ML)

Bulk Discount Available!

Eosin Y Solution, Alcoholic, 1 X 500 mL (HT110116-500ML)
MilliporeSigma® (Sigma-Aldrich)
$72.80
Earn points on this purchase
| form | solution |
| storage temp. | room temp |
| application(s) | hematologyhistology |
| concentration | 0.5 % (w/v) in acidified ethanol |
| IVD | for in vitro diagnostic use |
| Quality Level | 500 |
| shelf life | Expiry date on the label. |